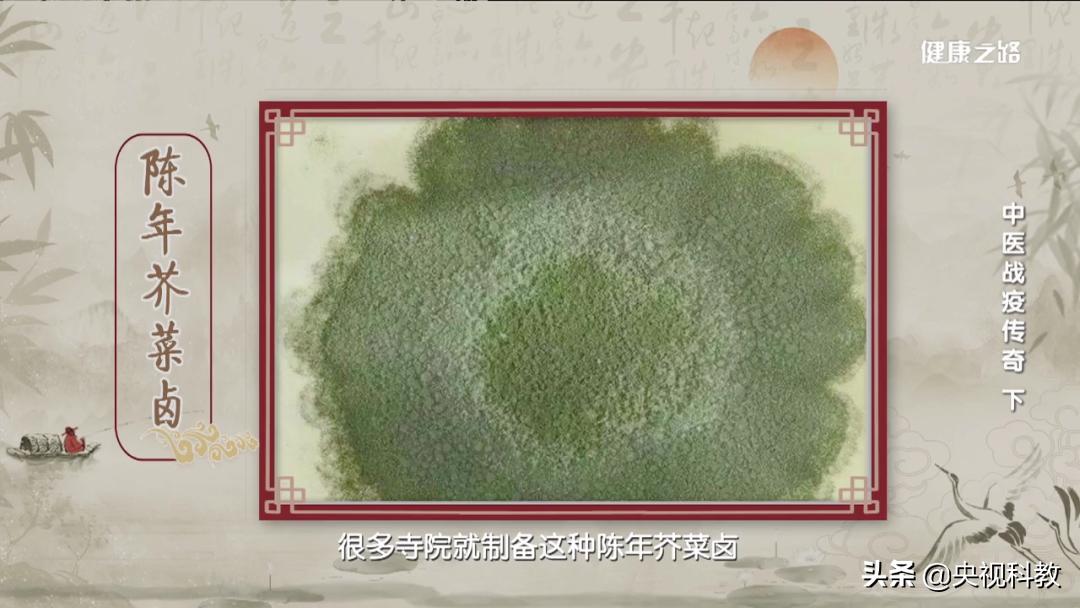
古方今用起良效，中医战疫有传奇

面对疫情,古代中医们积攒的宝贵经验,让我们心里有底、手中有方。当代中医们的勤于思考、勇于担当,让我们看到希望、守住健康。健康之路为您揭晓,中华民族在瘟疫抗争的历史中,那些优秀中医名家。

周继朴 主任医师
首都医科大学附属北京中医医院 呼吸科

温病大家——吴又可

明代崇祯年间,瘟疫肆虐,当时的医家运用张仲景的经方对抗瘟疫时效果不佳。温病大家吴又可经过研究,提出这次的流行病是温疫,不是伤寒。

吴又可认为瘟疫的病因不是“风、寒、暑、湿、燥、火”六邪之一,而是一种新的致病邪气,被他称作异气。异气的传播途径不是皮肤肌表,而是从人的口鼻。他的这种认识和现代医学认为传染病是由致病微生物引起的理论非常接近。

吴又可创立了非常著名的方剂——达原饮。达原饮中槟榔清除瘴气;草果芳香辟秽;厚朴理气化湿。在新冠肺炎的防治中,对于轻度、中度,表现以湿热为主的患者,中医建议使用达原饮。
达原饮在新冠疫情防治中运用的效果
温病大家——叶天士

清朝时,南方吴中一带流行霍乱,温病大家叶天士前往疫区治病。由于当时药物有限、病情蔓延迅速,他提出用灶心土和陈年的芥菜卤熬成水喝。

灶心土,中药也叫伏龙肝,灶心土经过火烧以后呈温性,有止泻、杀菌的作用。陈年芥菜卤即腌芥菜,其中含有青霉素,可以治疗肺炎、腹泻等感染性疾病。

叶天士在代表著作《温热论》中提出,温病从口鼻而入,会经卫、气、营、血四个层次,逐层深入、侵犯人体。根据病的不同层次,他提出了不同的治疗方法。在新冠肺炎的防治中,借鉴叶天士热入血分的学术思想,现代中医使用了血必净注射液。

血必净是2003年非典时研制的一种注射液,主要用于治疗感染到危重症阶段,如脓毒症、脓毒症休克等出现凝血功能障碍的患者。血必净中的红花、赤芍、川芎、丹参和当归都有活血凉血的作用。
血必净在新冠疫情防治中运用的效果
温病大家——吴鞠通

1793年,北京流行瘟疫传染病,出现大量的人口死亡,温病学家吴鞠通仔细分析当时传染病的特点,结合他多年学习的温病、伤寒治病经验,推出了一系列的治疗措施。

吴鞠通总结经验写成的《温病条辨》,是中医学的四部经典之一。现在大家常吃的银翘解毒片、银翘解毒颗粒、桑菊饮、安宫牛黄丸都出自其中。
吴鞠通理念
在新冠疫情防治过程中运用的效果

中医认为“三因制宜”,即疾病的发生、发展、变化和转归,受地理环境、季节气候、病人身体情况以及病人年龄的影响。要结合多方因素才能制定合理有效的治疗方案。

中医药学是历代中医药工作者与疾病不懈地斗争中取得的科学认识,是中华文化的精髓,无论是过去、现在还是将来,都将是人类战胜疾病不可或缺的有力*器武**。
健康提示:请出门戴口罩、勤洗手、多通风、少去人群密集处。
健康之路
《中医战疫传奇》(下)
播出时间:5月30日 18:05
更多相关精彩内容
在中国,每分钟有1.3人确诊为胃癌,1人因胃癌死亡,3个测试带你认清胃癌离你有多“近”|健康之路
高钠饮食、高血压、乱服中药是引发肾病的三大元凶!你中招了吗?|健康之路
错了!烫伤、切伤、被宠物咬伤后这样急救,简直是雪上加霜!|健康之路
骨质疏松不要动?3个运动处方告诉你科*运学**动很重要!| 健康之路
几乎100%的人都会得白内障!高度近视患者尤其要注意!丨健康之路
扫扫二维码 送你一个专业健康知识普及平台 ↓↓ ↓↓

监制 / 闫东 主编 /刘铭 黄丽君
编辑 / 任梦瑶 郭晓霞
推广
